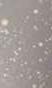

NIM ON 00€50 U 00,G ,ABZUG a 2) Gutscheine, Aktionsbedingungen und Ausnahmen auf Seite 2/3 1) Finanzierungsbeispiel: Kaufpreis/Gesamtkreditbetrag € 1 000, ; Laufzeit 60 Monate; 0,00 % Sollzins p a ergibt 0,00 % Effektivzins p a Rate € 16,67/Monat Gesamtbetrag € 1 000, Finanzierung ab einem Ein kaufswert von € 200, Bankübliche Bonitätskriterien vorausgesetzt Finanzierungsentscheidung obliegt unserer Partnerbank, der Santander Consumer Bank GmbH Gültig bis 21 11 2022 Weitere Infos auf kika at 0% FINANZIERUNG 0% BEARBEITUNG 0% ANZAHLUNG 0% ZINSEN Feiern Sie ER een e NG 6 60 0 MONATE ZINSFREI1) AT DASFINALE! CHEI2WERTV 1 30 JAHRE kikaLiezen,Ried, Mistelbach,Feldbach, Leoben 25 JAHREkika Imst, Stockerau, Wörgl, Dornbirn,Wien N rd 20 JAHRE WkikaWienOttakring, ienLaxenburgerstraße 20 JAHRE kika Wr Neustadt, Ansfelden 45 JAHRE kika St Pölten



































































































Stattpreise sind *unsere bisherigen Verkaufspreise. EEK = Energieeffizienzklasse 2 DIESE UND VIELE WEITERE e teilmas SCHWEBETÜRSCHRANK. Korpus und Absetzung Eiche Sonoma, Front alpinweiß. Griffleisten korpusfarbig. B 315 H 210 T 62 cm Schrankzusatzausstattung gegen Aufpreis. (23367544) 799 7 Inkl 2 Hängenachtkästchen Inkl 2x Bettkasten Inkl Topper B 315 cm 6-trg. Falttürschrank Inkl 4 Kleiderstangen und 4 Fachböden Komfortbett 180 x 200 cm WEITERE GRÖSSEN SCHNELL ABHOL BEREIT JUBILÄUMSPREISS! 20 JAHRE kika Wr Neustadt, Ansfelden 45 JAHRE kika St. Pölten 30 AHRE kaLiezen,Ried, elbach,Feldbach, Leoben GUTSCHEINE SPAREN! AUSSCHNEIDEN& UNGLAUBLICH! 999,,1.999, Feiern Sie M M GÜNSTIGER u, 20 HRE bOttakring, urgerstraße JA ki Miste Ü DASFINALE! 0% FINANZIERUNG 0% BEARBEITUNG 0% ANZAHLUNG 0% ZINSEN örgWie 6 60 0 MONATE ZINSFREI1) AT 1) Finanzierungsbeispiel: Kaufpreis/Gesamtkreditbetrag € 1.000,-; Laufzeit 60 Monate; 0,00 % Sollzins p.a. ergibt 0,00 % Effektivzins p.a.. Rate € 16,67/Monat. Gesamtbetrag € 1.000,-. Finanzierung ab einem Einkaufswert von € 200,-. Bankübliche Bonitätskriterien vorausgesetzt. Finanzierungsentscheidung obliegt unserer Partnerbank, der Santander Consumer Bank GmbH. Gültig bis 21.11.2022. Weitere Infos auf kika.at





























IHR GUTSCHEIN IM WERT VON 200 200, IHR GUTSCHEIN IM WERT VON €100,Ausgenommen in unseren aktuellen Prospekten und Inseraten beworbene Produkte AB EINEM EINKAUFSWERT VON € 500,AUF VIELE MÖBEL2) Gültig von 15 bis 21 11 2022 100ZUM SOFORTABZUG AKTIONSCODE 25035355 IHR GUTSCHEIN IM WERT VON 500 € 500,E 5389 G ,IHR GUTSCHEIN IM WERT VON € 25,AB EINEM EINKAUFSWERT VON € 100, 3) AUF VIELE ARTIKEL AUS DER RAUMAUSSTATTUNG WIE Z.B. HEIMTEXTILIEN, KOCHGESCHIRR, LEUCHTEN UVM. € 25,ZUM SOFORTABZUG AKTIONSCODE 25035347 Gültig von 15 bis 21 11 2022 ‹ } g 5 / › 2 5 0 3 5 3 4 7 IHR GUTSCHEIN IM WERT VON 1000€1.000, ANGEBOTE AUF KIKA.AT , BOXSPRINGBETT Stoff aqua. Liegefläche 180 x 200 cm. Kopfhaupt Quadra. Box Cubic. Füße Metall chrom. Topper, Beimöbel und Motor gegen Aufpreis. (24652910) Inkl 2x Taschenfederkern Matratze IRALCARE kann es zu einer Re g der antiviralen Aktivität und Erhöhung der antibakteriellen mkeit kommen H2 + H3 preisgleich MATRATZE. 7 Zonen Tonnen Taschenfeder kern Bi elastischer Bezug Seitliches 3D Klimaband 90 x 200 cm (24875695) LÄUMSPREISS! 199, * 28% 2.299,2/3) Pro Person und Einkauf ist nur ein Gutschein gültig Nicht in bar ablösbar Vor dem Einkauf bitte bei einem Berater melden, eine nachträgliche Anrechnung ist leider nicht möglich Ausgenommen in unseren aktuellen Prospekten und Inseraten beworbene Produkte, Warengutscheine, Serviceleistungen, in den Einrichtungshäusern gekennzeichnete Unglaublich Preise, Dauertiefpreise, Werbepreise und Trends by kika Produkte, bereits reduzierte Artikel, Küchen blöcke, Stressless, Team 7, Anrei, Stokke, Schöner Wohnen, Leuchtmittel,
499,679,Sie sparen -27% PREISHAMMER! PRE Per Stk 0%1) FINANZIERUNG 60x 8,32 monatlich WASCHBAR 40° MIT ZIPP Ausgenommen in unseren aktuellen Prospekten und Inseraten beworbene Produkte
Tom Tailor, Set One by Musterring, Schösswender Katalogbestellungen, Grüne Linie, Badewannen, Duschen, Voglauer, Henders & Hazel, Leonardo, Austroflex, Tempur, Musterring, Nemec, Joop!, Hülsta, Elektrogeräte und Zubehör 2) Ausgenommen in unseren aktuellen Prospekten und Inseraten beworbene Produkte, Warengutscheine, Serviceleistungen, in den Einrichtungshäusern gekenn bereits reduzierte Artikel, Tom Tailor, Schöner Wohnen, Marc O` Polo, WMF, Villeroy & Boch, Elektrogeräte und Zubehör, Bugaboo, Leuchtmittel, ur, Bücher, Nemec, ASA. Gilt nur für Neuaufträge und ist nicht mit anderen Aktionen kumulierbar Auch im Onlineshop mit Aktionscode einlösbar


















Stattpreise sind *unsere bisherigen Verkaufspreise. EEK = Energieeffizienzklasse 4 DIESE UND VIELE WEITERE 899,UNGLAUBLICH! TV UNTERTEIL Front Balkeneiche Bianco stattung gegen Aufpreis Ca B 210 H 68 SITZGRUPPE. Stoff gelb. Rücken echt. Inkl. Bettfunktion, Zeitungstasche, 5x Rücken- und 3x Zierkissen. Ca. 248 x 176 cm. (24329543, 24329551, 24337885, 24337893) MEHR FARBEN MIT AUFPREIS € SCHNELL ABHOL BEREIT Front Holz massiv JUBILÄUMSPREISS! 3-SITZER 1)
Kaufpreis/Gesamtkredit-
Partnerbank,
Consumer
Infos
2-SITZER 0%1) FINANZIERUNG 60x 14,98 monatlich 0%1) FINANZIERUNG 60x 24,90 monatlich BESTSELLER kika.at In Ihrer Online-Filiale und bei allen kika Einrichtungshäusern erhältlich. 699,9,-
Finanzierungsbeispiel:
betrag € 1.000,-; Laufzeit 60 Monate; 0,00 % Sollzins p.a. ergibt 0,00 % Effektivzins p.a.. Rate € 16,67/Monat. Gesamtbetrag € 1.000,-. Finanzierung ab einem Einkaufswert von € 200,-. Bankübliche Bonitätskriterien vorausgesetzt. Finanzierungsentscheidung obliegt unserer
der Santander
Bank GmbH. Gültig bis 21.11.2022 Weitere
auf kika.at

















ANGEBOTE AUF KIKA.AT IHR GUTSCHEIN IM WERT VON 0 AB A €500,DE 89 UG SITZGRUPPE Stoff blau Rücken echt Inkl Sitztiefenverstellung Ca 315 x 260 cm. Gegen Aufpreis: Funktion und Zubehör (24669618, 24669501, 24669519) dunkel ax. Be123533) massiv, Oberflächen geölt Zusatzaus T 50 cm (24374374 24174237 24174261) 5, WOHNWAND. Korpus und Front arktisgrau matt Melamin/Nachbildung. Zusatzausstattung gegen Aufpreis. Ca. B 270. H 208. T 50 cm. (24414485, 24414550, 24414576),799,799, 1.199,PREISBEISPIEL Inkl. Oberboden Beleuchtung Wohnwand cher und e Inkl. Türdämpfung 1.699,1.69 , Aktionsbedingungen und Ausnahmen auf Seite 3! GUTSCHEINAUSSCHNEIDEN&SPAREN! 0%1) FINANZIERUNG 60x 19,98 monatlich 0%1) FINANZIERUNG 60x 13,32 monatlich NURBEIUNS! FUNKTIONSFAUTEUIL.
grau.
manu-
Verstellung.
T 87 cm.
Aufpreis Funktionen und
24251051
Stoff
Inkl.
eller
Größe Small. Ca. B 73. H 106.
Gegen
Zubehör (24679253, 24251043,
VORZIMMER. Mango-Holz massiv Inkl. Messingapplikationen. Sitzbank. Ca. H 48. T 40 cm. 199,-. Paneel. Ca. B 90 249,-. Schuhkommode. Ca. B 90 cm. 499,-. Spiegel. Ca. B 90 139,-. Garderobenschrank. Ca. B 100 999,- (23264518, 23264253, 23264401, 23264576, 23264609)




















Ca. 180-225 x 90 cm.
1.499,-.
Stoff
24291685, 24292865) Stattpreise sind *unsere bisherigen Verkaufspreise. EEK = Energieeffizienzklasse 6 DIESE UND VIELE WEITERE Sessel ohne Armlehne K E i ffi i kl SCHNELL ABHOL BEREIT SCHNELL ABHOL BEREIT 229,119, , 9,BESTSELLER! SCHNELL ABHOL
SESSEL. Tisch.
Tischplatte massiv, Wildeiche Natur geölt. Bodenplatte schwarzgrau.
Sessel. Gestell schwarz matt lackiert. Bezug
verschiedene Farben. 119,-. Mit Armlehne. 189,- (24291669,
MASSIV HOLZ Sitzbank Schuhkommode Große Farb- und Typenauswahl
DREHSESSEL. Stoff Samt grau. (23706560)
0%1) FINANZIERUNG 60x 3,31 monatlich JUBILÄUMSPREISS! 119,11
DREHSESSEL. Bezug schwarz/ rot. Rückenlehne 135° verstellbar Inkl. 2 Kissen. (20226628)
1) Finanzierungsbeispiel: Kaufpreis/Gesamtkredit betrag € 1.000,-; Laufzeit 60 Monate; 0,00 % Sollzins p.a. ergibt 0,00 % Effektivzins p.a.. Rate € 16,67/Monat. Gesamtbetrag € 1.000,-. Finanzierung ab einem Einkaufswert von € 200,-. Bankübliche Bonitätskriterien vorausgesetzt. Finanzierungsentscheidung obliegt unserer Partnerbank, der Santander Consumer Bank GmbH. Gültig bis 21.11.2022. Weitere Infos auf kika.at






















ANGEBOTE AUF KIKA.AT IHR GUTSCHEIN IM WERT VON 0 200G E 5363 GUTSCHEINAUSSCHNEIDEN&SPAREN! ab 99.99
JUBILÄUMSPREISS!299,Stattpreise sind *unsere bisheri
ab149,-
Selbsteinzug
Aktionsbedingungen und Ausnahmen auf Seite 3!
und




























ist nur ein Gutschein gültig und wird sofort von der Rechnung abgezo gen Nicht in bar ablösbar Vor dem Einkauf bitte bei einem Berater melden, eine nachträgliche Anrechnung ist leider nicht möglich Bei Ein lösung können keine weiteren Konditionen ge währt werden Ausgenommen in Inseraten und Prospekten beworbene Artikel, Warengutscheine, Serviceleistungen, in den Einrichtungshäusern gekennzeichnete Unglaublich Preise, Dauertief preise, Werbepreise und Trends by kika Produkte, bereits reduzierte Artikel, Stokke, Elektrogeräte/ Zubehör, Leifheit, WMF, Villeroy & Boch, Leucht mittel, Fissler, Grüne Linie, Joop!, Tom Tailor, Tempur, Laminat , Parkett und Vinylboden, Le bensmittel, Bücher, Marc O Polo, ASA, Schöner Wohnen Gilt nur für Neuaufträge und ist nicht mit anderen Aktionen kumulierbar Auch im On lineshop mit Aktionscode einlösbar

IHR GUTSCHEIN IM WERT VON €25,Ausgenommen in unseren aktuellen Prospekten und Inseraten beworbene Produkte AB EINEM EINKAUFSWERT VON € 100, 3) AUF VIELE ARTIKEL AUS DER RAUMAUSSTATTUNG WIE Z B. HEIMTEXTILIEN, KOCHGESCHIRR, LEUCHTEN UVM. G b 3)
Gültig von 15 bis 21 11 2022 Näheres auf kika at GUTSCHEINAUSSCHNEIDEN&SPAREN! Wien Wien Laxenburgerstraße 01/60130 Wien Nord 01/25005 Wien Ottakring 01/48848 Niederösterreich Horn 02982/53073 Mistelbach 02572/5004 St. Pölten 02742/74535 Stockerau 02266/698 Wr Neustadt 02622/383 Oberösterreich Ansfelden 07229/212 Linz/Urfahr 0732/730941 Ried-Aurolzmünster 07752/907 Burgenland Eisenstadt 02682/778 Unterwart 03352/31650 Salzburg Eugendorf 06225/3300 Saalfelden 06582/76340 St. Johann/Pg. 06412/4664 Steiermark Feldbach 03152/6161 Graz 0316/282556 Leoben 03842/83440 Liezen 03612/26677 Kärnten Klagenfurt 0463/3840 Vorarlberg Dornbirn 05572/51616 Tirol Imst 05412/606 Innsbruck/Neu-Rum 0512/2404 Lienz/Nußdf.-Debant 04852/67555 Wörgl 05332/7870 Aufgrund unterschiedlich großer Verkaufsflächen sind in Ausnahmefällen einzelne Produkte nur gegen Bestellung erhältlich Impressum: Herausgeber und Medieninhaber (Verleger): Leiner & kika Möbelhandels GmbH, Porschestr 7, 3100 St. Pölten. Hersteller: EDS Zrínyi Zrt., H-2600 Vác, Nádas utca 8 Leiner & kika Möbelhandels GmbH, Porschestr 7, A-3100 St. Pölten, FN 415688g. Alle Preise sind Abholpreise, gültig von 15. bis 21.11.2022 bzw solange der Vorrat reicht. Vorbehaltlich Satz- und Druckfehler Alle angeführten Preise ohne Deko-Material. 11-2022/220220. Stattpreise sind *unsere bisherigen Verkaufspreise. g H! 14.99 24,99* Sie sparen -40% PREISHAMMER! PRE DECKENLEUCHTE. Glas satiniert mit Dekor Ca. L 24. B 24 H 15 cm Exkl Leuchtmittel (17465304) 25% 9 BETTWÄSCHE. 70 x 90 cm. 140 x 200 cm. 100% feinste BW Satin (24623127, 24623276) PO 52 Fa GANZJAHRESDECKE. Füllung: (19114834, 19. 9.99 29,99* Sie sparen -33% PREISHAMMER! WOCHENHIT!
Pro Person
Einkauf